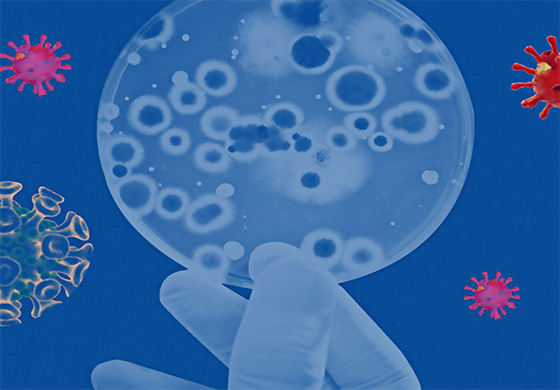

මෙරටදී ඔමික්රෝන් ආසාදිතව හඳුනාගෙන ඇති රෝගියා මෙරටට පැමිණි සංචාරකයෙක් නොව දකුණු අප්රිකාවේ සිට මෙරටට පැමිණි ශ්රී ලාංකිකයකු බවට හඳුනාගෙන ඇතැයි ද, මෙරටට පැමිණීමට තහනම් කර ඇති රටවල් 06 න් පසුගිය දින 21 ක කාලයේ දී මෙරටට කිසිදු සංචාරකයකු පැමිණ නැතැයි ද සංචාරක ඇමැති ප්රසන්න රණතුංග මහතා පැවසීය.
මේ වන විට කටුනායක ගුවන් තොටුපළ තුළ එන්නත් දෙකම ලබාගෙන ඇති සංචාරකයන් රටට ඇතුළත් කර ගැනීම සිදුකරන බවත්, රටට පැමිණෙන සියලූම සංචාරකයන් පී.සී.ආර්. පරීක්ෂණයකට යොමුවිය යුතු යැයි සෞඛ්ය අමාත්යාංශ නිර්දේශ කරනවා නම් ඒ අනුව කටයුතු කිරීමට සංචාරක අමාත්යාංශය කටයුතු කරන බවත් ඇමැතිවරයා කීය.
සංචාරක අමාත්යාංශය රටට සංචාරකයන් ගෙන්වා ගැනීම සෞඛ්ය අමාත්යාංශය ලබාදී තිබෙන උපදෙස් අනුව බව ද කී ඒ මහතා මේ වසරේ නොවැම්බර් 30 වැනි දා වන විට සංචාරකයන් එක්ලක්ෂ පන්දහසක් රටට පැමිණ ඇතැයි ද පැවසීය.

ඉන්දු - ලංකා ගිවිසුම නීති විරෝධී ගිවිසුමක් බවත්, ඒකීය රට ෆෙඩරල් කිරීම හරහා බෙදීමට කිසිසේත්ම ඉඩදිය නොහැකි බවත් මහා විහාර වංශික ශ්ය...

අනුරාධපුර දිස්ත්රික් පාර්ලිමේන්තු මන්ත්රී ජනප්රිය රංගන ශිල්පී උද්දික ප්රේමරත්න මහතාගේ මෝටර් රථයට කිසියම් ...

රජිව් ගාන්ධි ඝාතනය සම්බන්ධයෙන් වරදකරුවන් වී දඬුවම් ලැබ සිට පසුව නිදහස ලැබූ ශ්රී ලාංකිකයන් 4 දෙනා නැවතත් ශ්රී ලංකාවට එවීමට...